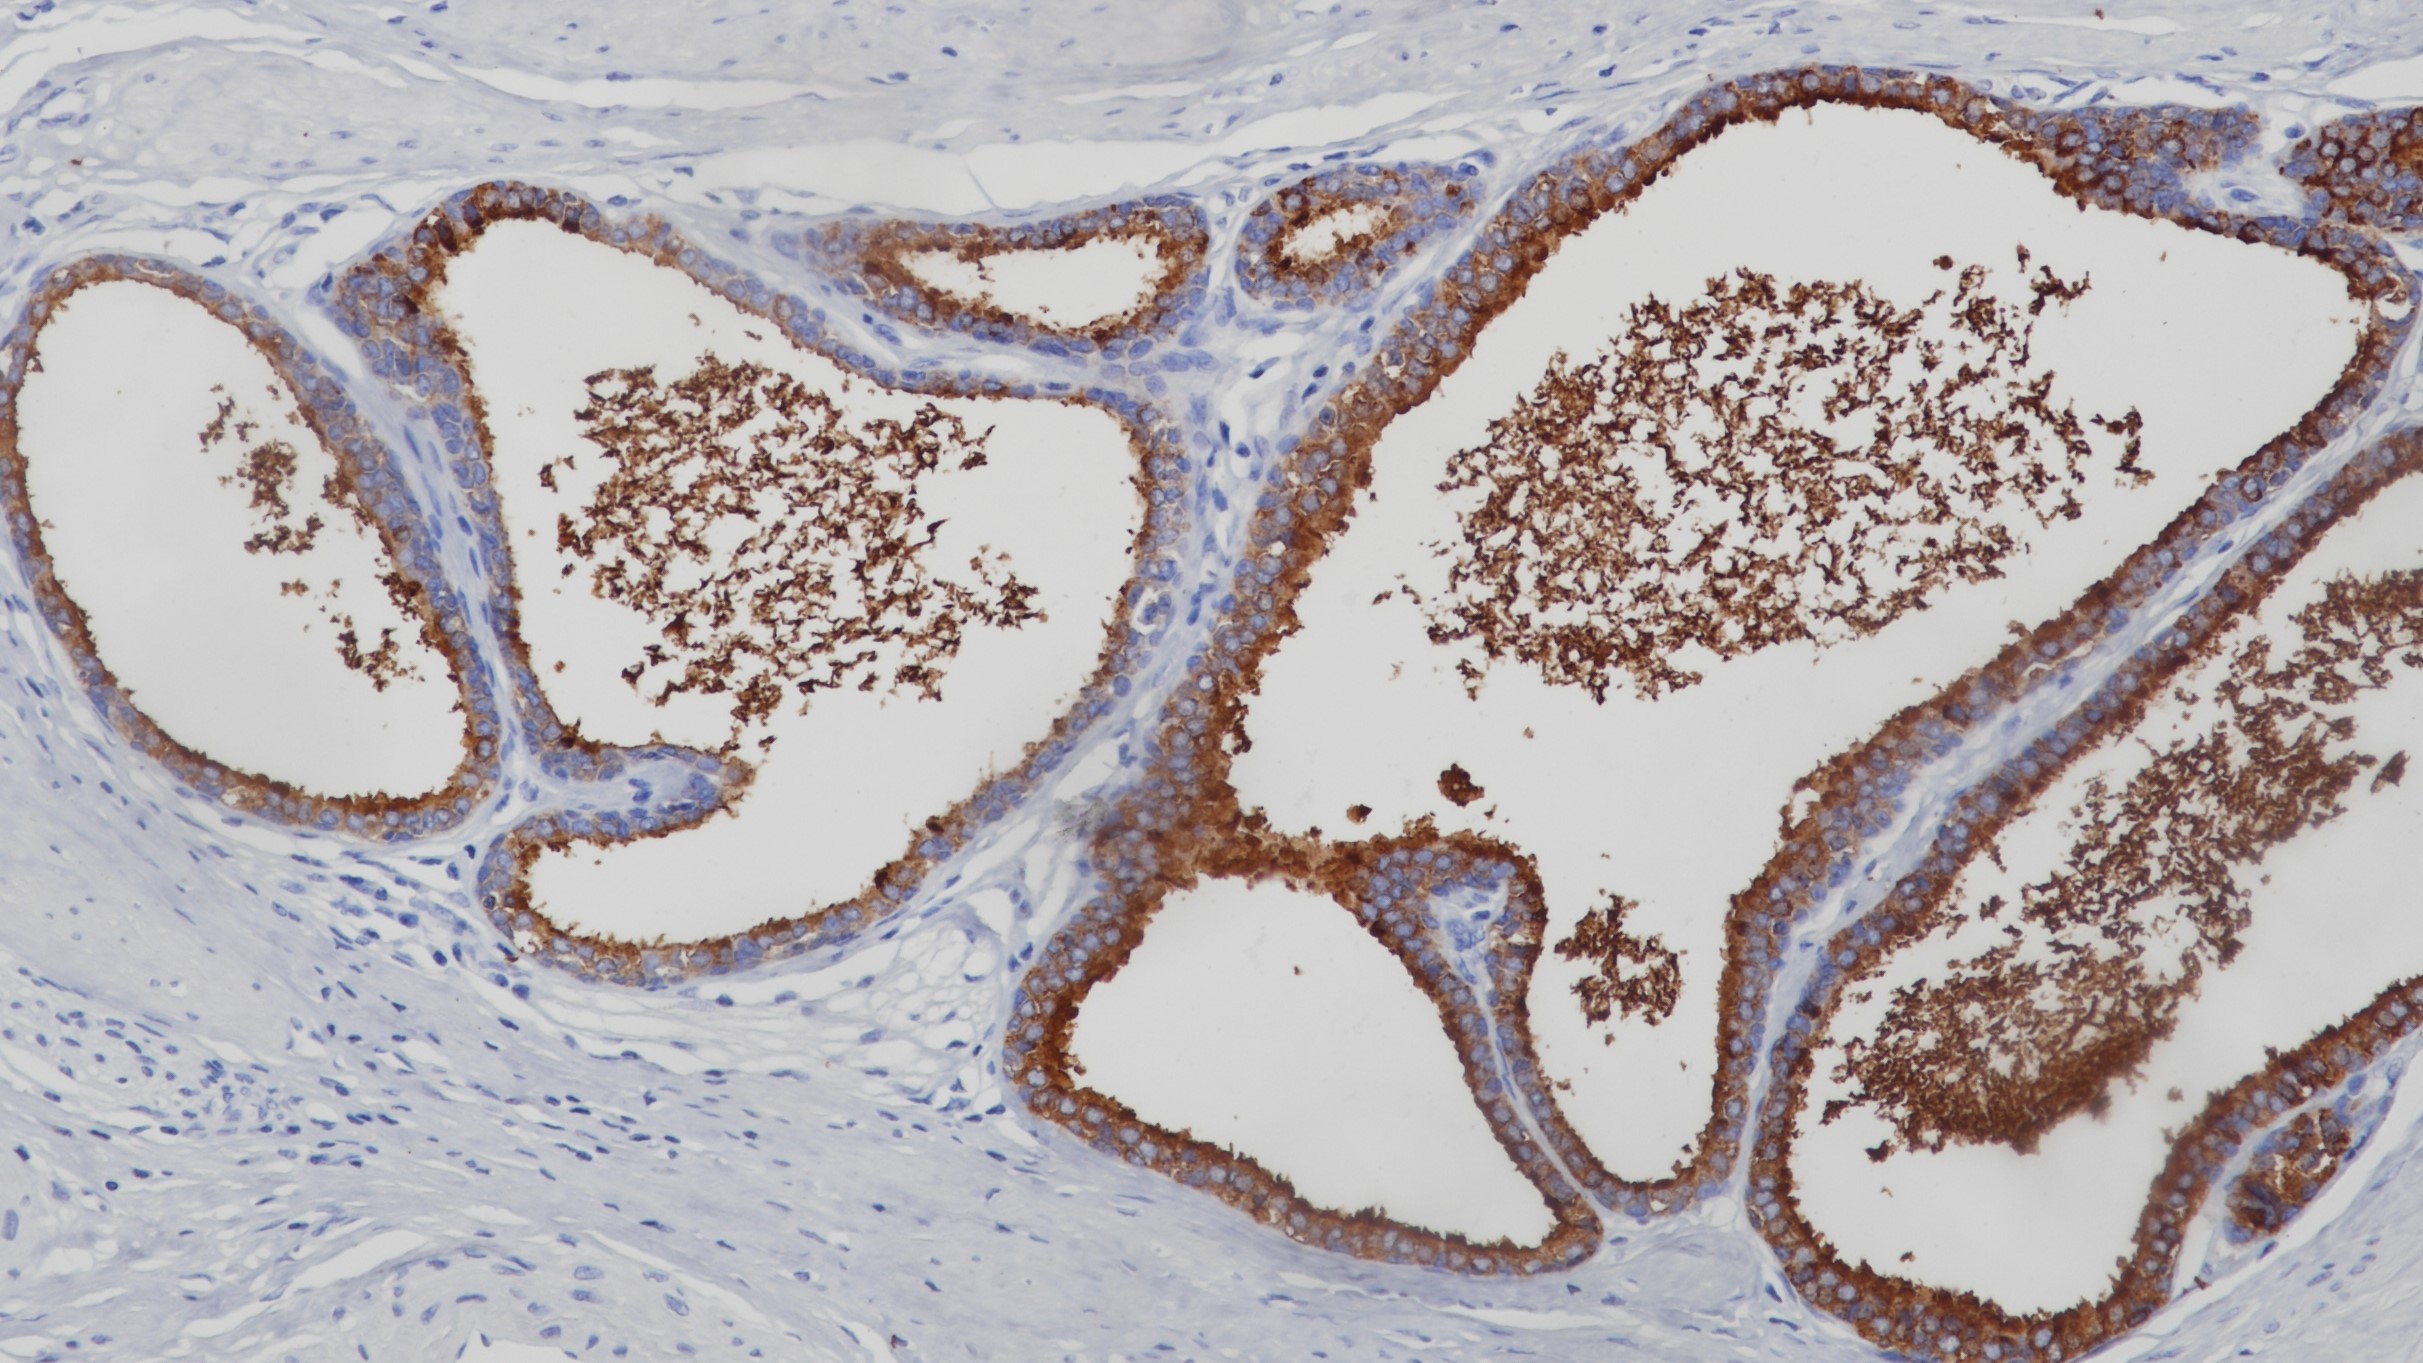
前列腺PSAP(BP6050)染色

产品中心

前列腺癌PSAP(BP6050)染色
前列腺PSAP(BP6050)染色
PSAP 重组兔单克隆抗体
PSAP(PAP,前列腺酸性磷酸酶)是组氨酸酸性磷酸酶家族成员之一。它是一种非特殊的磷酸酶,能够在轻度酸性环境下去除酪氨酸残基和磷脂。PSAP与前列腺上皮分化有关。它在前列腺、原发性前列腺癌和前列腺转移性癌中高度表达。这个标记可能有助于在前列腺转移癌的病例中准确地指出来源的位置,并且被认为是比PSA更敏感的标记。
Specifications
- 产品注册名称
- PSAP抗体试剂
- 目录号
- I1023
- 克隆号
- BP6050
- 亚细胞定位
- 细胞质
- 阳性对照
- 前列腺癌
- 修复方式
- HIER
- 组织类型
- FFPE
- 规格
- 工作液:1.5mL/7mL
浓缩液:0.1mL/1mL
- 用途
- NMPA IVD
CE
Applicable platform
- Biolynx平台
- Leica平台
- Roche平台
- Dako平台
Reference
1.Genega EM, et al. Mod Pathol. 2000 Nov;13(11):1186-91.
2.Street, S.E, et al. (2013) J Neurosci 33, 11314-22.


